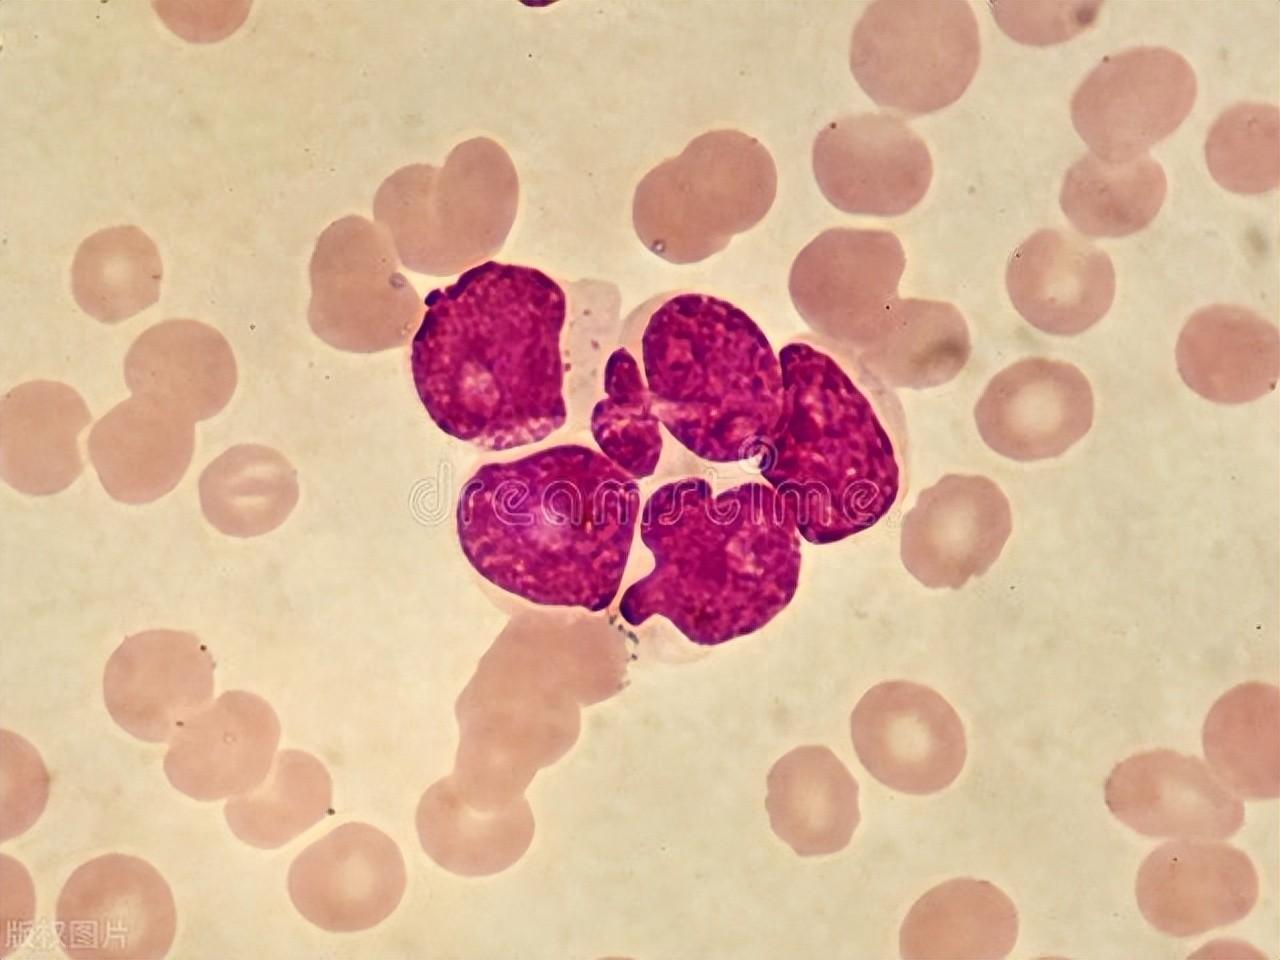

“白血病”專挑孩子下手,建議:這3種食物,孩子再饞也別買
我國經濟高速發展的幾十年來,有一個問題暴露得越來越明顯,那就是各種疾病的低齡化。曾經四五十歲纔會出現的病症,在新生兒上也會出現。就拿白血病來說,每年我國都有超過一萬五的新增病例,幾乎和成年人持平。
白血病是屬於造血系統的惡性疾病,是最危險的癌症之一。在中國,每10萬兒童中就有4名白血病患者,兒童白血病佔整個兒童惡性腫瘤的1/3左右,而且大多是學齡前兒童,這值得我們每一位父母關注。
白血病有治癒的可能性嗎?
對於部分類型的白血病患者而言,通過及時的綜合治療,包括化療、靶向治療、免疫治療乃至造血幹細胞移植等先進手段,完全有可能達到臨牀治癒的標準,即體內無殘留白血病細胞,恢復正常生活狀態。
然而,也有部分患者,尤其是某些高危或難治性白血病患者,雖然難以實現徹底治癒,但通過科學的治療方案,可以有效控制病情,抑制癌細胞的增殖與擴散,使患者能夠長期帶瘤生存,且生活質量不受顯著影響。

所以說,白血病的治療雖然複雜且充滿挑戰,但在醫學科技的不斷進步下,患者的治癒可能性和生存質量正在穩步提升,爲更多患者帶來了生命的曙光。
導致兒童白血病增多的3個原因
一、環境因素
環境因素被認爲是兒童白血病發生的重要誘因之一。近年來,越來越多的研究表明,兒童所暴露的某些環境污染物可能與白血病的發病有直接關係。這種物質廣泛應用於化工、製藥等行業。
隨着城市化進程加快,兒童生活環境的變化也可能影響其健康狀況。城市中較高的污染水平、交通噪音以及生活方式的改變,可能對兒童的免疫系統產生負面影響,進而讓白血病有機可乘

二、遺傳因素
遺傳因素在兒童白血病的發生中也扮演着重要角色。一些遺傳綜合症,如唐氏綜合症、Fanconi貧血和瑞特綜合症等,已被證實與白血病的發生有顯著關聯。這些綜合症通常伴隨着免疫系統的異常,可能導致兒童更易感染和其他健康問題,從而增加白血病的風險。
若家庭中有白血病患者,其他成員罹患該病的風險會相對增加。這可能與遺傳因素及環境暴露的共同作用有關,尤其在同一家族中,兒童可能會面臨類似的環境和生活方式。

三、病毒感染
病毒感染在兒童白血病的發生中同樣被認爲是一個值得關注的因素。某些病毒感染可能會影響兒童的免疫系統,導致其對其他感染的抵抗力降低,從而增加白血病的風險。免疫系統的異常可能導致血液細胞的異常增殖,進而引發白血病。

這3種水果,孩子再饞也別買
一、加工肉製品
加工肉製品如熱狗、香腸、培根等,因其口感豐富、方便快捷,常常成爲孩子們的最愛。然而,這類食物通常含有高量的亞硝酸鹽和防腐劑,而這些成分被認爲與多種癌症,包括白血病,有一定關聯。
二、含有人工添加劑的零食
市場上各種各樣的兒童零食琳琅滿目,尤其是那些色彩鮮豔、口感獨特的糖果和薯片,深受孩子們的喜愛。然而,這些零食往往含有大量的人工添加劑,如色素、防腐劑等。

根據最新的科學研究,某些食品中的人工色素和防腐劑已經被證明對兒童的免疫系統產生負面影響。兒童的免疫系統尚未發育完全,過多攝入這些化學成分可能導致免疫功能失調,進而增加白血病的風險。
三、含有高糖分的飲料
含糖飲料如碳酸飲料、果汁飲料等,因其口感甜美,常常成爲孩子們的“寵兒”。研究顯示,高糖飲食與多種健康問題相關,包括肥胖、代謝綜合症等,而這些健康問題又與某些癌症的發生有緊密聯繫。兒童時期的過量糖攝入,可能導致體內炎症反應增加,進而影響免疫系統的功能,增加白血病的風險。

兒童白血病的增多是一個複雜的公共衛生問題,涉及多種因素的相互作用。爲了有效預防兒童白血病的發生,我們需要進一步加強對這些因素的研究,同時提高公衆的健康意識,創造一個更安全的生活環境。

















